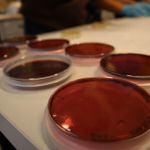

MOLBIB
...v roce 2024 se nekoná...
Molekulární biologie je moderní a rychle se rozvíjející disciplína. Studenti, kteří chtějí nahlédnout pod pokličku metodám, které se v jejím rámci používají, mají šanci na této týdenní akci s názvem Molekulární biologie v Budějovicích (zkráceně MOLBIB).
Metody molekulární biologie jsou mocným nástrojem, který nám umožňuje zkoumat živý svět na úrovni molekul DNA, RNA nebo proteinů. Cílem této týdenní akce je umožnit středoškolským studentům vyzkoušet si vlastníma rukama některé metody, které jsou běžně používané ve vědeckých nebo diagnostických laboratořích a se kterými se studenti ve škole nemají příležitost setkat kvůli jejich finanční a časové náročnosti. Akci vyhlašujeme jednou ročně (zpravidla v březnu nebo v dubnu), studenti jsou vybíráni na základě motivačního dopisu. Vyhlášení dalšího termínu sledujte v sekci Aktuality.
Reportáž z MOLBIBu 2023
Přírodovědecká fakulta Jihočeské univerzity přivítala v týdnu od 5. do 9. června čtrnáct nadšených středoškolských studentů, kteří se zúčastnili akce Molekulární biologie v Budějovicích (MOLBIB). Toto laboratorní soustředění bylo pro studenty úvodem do světa molekulární a buněčné biologie a genetiky a prakticky představilo studentům mnoho moderních výzkumných metod včetně sekvenování DNA.
Program MOLBIBu se odehrával v prostorách Katedry molekulární biologie a genetiky, převážně v laboratoři Petra Nguyena. Studenti si vyzkoušeli telomerickou fluorescenční in situ hybridizaci (FISH) na preparátech bource morušového pod dohledem Moniky Hospodářské a Magdalény Vališové. Také si připravili preparáty z testes sarančat a pozorovali proces meiózy. Pomocí real-time PCR účastníci identifikovali přítomnost včelího viru, čímž je provedly Alena Bruce Krejčí a Karolína Svobodová, které pro studenty připravily také zajímavou přednášku o včelách. Účastníci se také blízce seznámili s modelovým organismem Drosophila melanogaster a prohlédli si fagocytující makrofágy pod konfokálním mikroskopem společně s Adamem Bajgarem a Gabrielou Krejčovou.
Významnou součástí programu MOLBIBu bylo sekvenování technologií Oxford Nanopore. Experiment měl za cíl detekovat druhové složení bakterií v prostředí kolem nás, například na klikách, stolech, záchodovém prkénku, držadlech v autobuse nebo na banánech z obchodu. Studenti si sami prošli celým procesem od kultivace bakterií, izolaci DNA, přes přípravy sekvenační knihovny a nanesení vzorku na sekvenátor MinION až po bioinformatickou analýzu získaných sekvenačních dat. Podařilo se identifikovat několik desítek druhů bakterií, včetně mnoha známých patogenů. Tuto část vedly Kseniya Bobryshava a Aneta Pilíková. Studenti se také dozvěděli více o současných sekvenačních technologiích díky přednášce Petra Nguyena.
Nabitý, převážně praktický program byl doplněn i dalšími přednáškami. Martin Janda si pro studenty připravil téma „Rostlina jako pevnost - aneb jak se bránit, když vás všechno chce sežrat“, čímž studentům poskytl nový pohled na obranné mechanismy rostlin. Účastníci také prohloubili své znalosti o virech, neboť Ondřej Lenz je s nimi seznámil v rámci přenášky s názvem „Kde se tady vzaly? Aneb vznikl Covid v laboratoři?“.
Studenti, kteří se MOLBIBu zúčastnili, byli ze všech koutů České republiky (i ze Slovenska), proto měli ubytování zajištěno na koleji K3 a stravovali se v menze JU. Středoškoláci si také prohlédli centrum Českých Budějovic, zasoutěžili si o ceny při vědeckém kvízu a dalších doprovodných hrách.
MOLBIB v Budějovicích tak přinesl nejen vzrušující a poučný program, ale také příležitost pro mladé nadějné vědce seznámit se s prostředím Přírodovědecké fakulty Jihočeské univerzity, nakouknout pod pokličku vysokoškolského života a osvojit si celou řadu laboratorních dovedností. Akci organizačně zajistila Aneta Pilíková s pomocí Kseniye Bobryshavy. Děkujeme všem, kteří se na uskutečnění letošního MOLBIBu podíleli.
V uplynulých ročnících si vždy patnáct studentů vyzkoušelo metody, které se pro svojí časovou (i finanční) náročnost obvykle předvádějí až ve specializovaných kurzech pro studenty molekulární biologie na vysokých školách. Pomocí fluorescenční in situ hybridizace s malovací sondou jsme na chromosomálních preparátech z obaleče jablečného hledali (a našli) pohlavní chromosom W, ze zástupců různých hmyzích řádů jsme vyizolovali DNA a pak metodou dot blot hybridizace zjišťovali, jakou sekvenci mají konce jejich chromosomů čili telomery, a nakonec si všichni z vlastní mitochondriální DNA, izolované z vlasových kořínků, namnožené metodou PCR a osekvenované, zjistili, k jakému mitochondriálnímu haplotypu patří, neboli která z dcer Eviných byla jejich praprapra...babičkou.
V případě dotazů k této akci kontaktujte Evu Gardianovou (